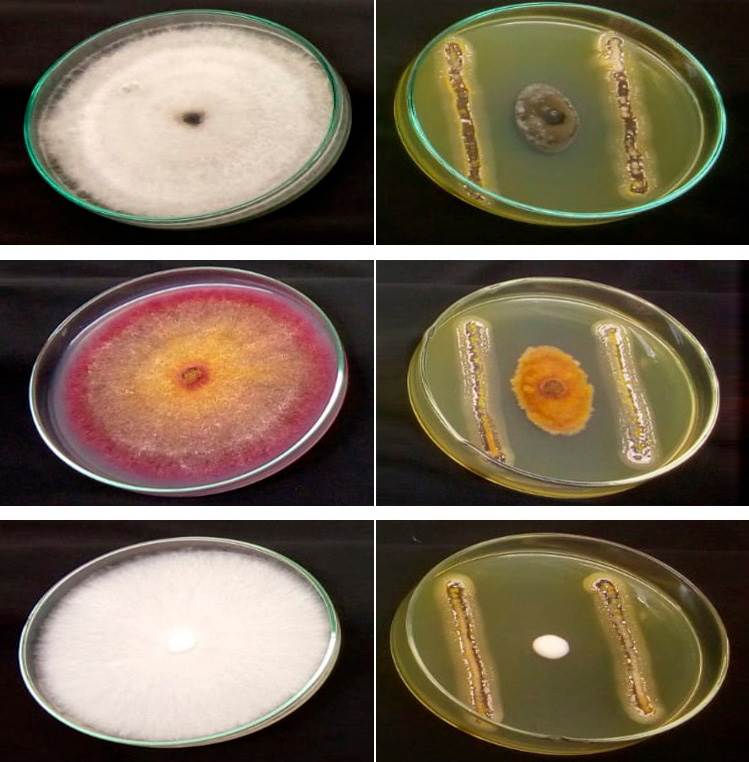

-
Publicado originalmente por Página 22
A Amazônia representa 60% do território brasileiro, e não à toa é tida como uma terra de superlativos. Lá tudo é grande: o rio mais caudaloso do globo terrestre, o Amazonas; as muitas curvas do mais sinuoso, o Juruá, habitat dos maiores de todos os peixes de água doce existentes – o pirarucu, de escama, e a piraíba, de couro. E a lista não para por aí.
Além de abrigar a maior concentração de índios isolados do mundo, no entorno do Rio Javari, e a mais rica biodiversidade, a região se destaca pelo tamanho das distâncias, do isolamento, dos desafios.
Os estoques naturais guardam árvores grandes e numerosas o suficiente para o controle climático global e garantia de chuva que abastece cidades e sustenta, em outras regiões brasileiras, a atividade que representa quase um terço da economia nacional, o agronegócio. Mas o desmatamento, também superlativo, já levou um naco de 16% a 17% da vegetação original e permanece voraz, com impactos perto de atingir o ponto de não retorno.
Na mais extensa floresta tropical do planeta salta aos olhos a portentosa sumaúma, uma das mais altas árvores da Terra, e lá viceja a maior folha já classificada pelos cientistas, da espécie Coccoloba gigantifolia, com seus 2,5 metros de comprimento. Isso é o que a gente vê.
O apelo visual impressiona, mas talvez a principal riqueza de todas possa estar longe das grandiosidades, e sim na Amazônia invisível: o mundo desconhecido da microfauna escondida na forma de fungos, bactérias e outros organismos presentes no oco dos troncos, solo, leito dos rios – minúsculos e ocultos, mas não menos importantes ao equilíbrio ecológico e à qualidade de vida humana.
Ao contrário, trata-se de uma matéria-prima altamente cobiçada pela biotecnologia para processar e desenhar moléculas de maneira que a biodiversidade se transforme em produtos destinados a prevenir e curar doenças, combater pragas, produzir alimentos mais nutritivos e acessíveis, gerar energia e até tratar resíduos urbanos, na perspectiva de uma nova matriz de desenvolvimento econômico.
Ao chegar ao mercado e à rotina dos consumidores, esses elementos originariamente escondidos tornam-se aparentes e despertam para uma maior valorização do que vem da floresta, aquela mantida em pé e não derrubada por atividades causadoras de desmatamento. A lógica virtuosa inspira o trabalho de grupos de pesquisadores que erguem pontes para a ciência sair dos laboratórios, romper muros acadêmicos e chegar à sociedade em busca de uma vida mais sustentável.
Demandas da pandemia abre portas para a biotecnologia
A pandemia de Covid-19 chamou atenção para o desafio. Foi do contato entre pessoas e animais silvestres que o novo coronavírus saiu para contaminar 16,5 milhões de pessoas no mundo e 2,4 milhões no Brasil, até julho de 2020. E pode vir das florestas parte importante das soluções à prevenção e enfrentamento desta e de futuras pandemias – fronteira que tem levado startups e instituições de pesquisa da Amazônia a olhar para o redor, rever projetos e desenvolver localmente novas linhas de inovação.
“Buscamos soluções de saúde pública e, ao mesmo tempo, oportunidades para movimentar uma nova economia na Amazônia”, afirma Carlos Koury, diretor-técnico do Idesam e coordenador do Programa Prioritário de Bioeconomia (PPBio), voltado a investimentos em inovações de startups e institutos de ciência e tecnologia com recursos repassados pelas indústrias de informática como contrapartida obrigatória pela isenção fiscal da Zona Franca de Manaus. Diante das demandas da pandemia, o mecanismo ganhou uma linha especial: o PPBio-Procovid com facilidades de acesso para apoio a projetos inovadores específicos no campo da saúde.
As soluções vão do álcool em gel com óleo de copaíba a softwares para gestão de leitos de UTI, de modo a contribuir não somente à mitigação da atual pandemia, como também à prevenção e ao tratamento de doenças que estão por vir. Além de oferecer oportunidade ao engajamento de empresas no combate à Covid-19 com apoio a tecnologias, “o objetivo é demonstrar resultados com potencial de novos mercados”, explica Koury. A expectativa é captar investimento total de R$ 24,7 milhões até o fim do ano, inclusive para projetos apresentados por centros de pesquisa baseados na microbiota amazônica.
Sobre essa natureza invisível recai o desafio de formar cérebros, atrair parcerias e criar a infraestrutura de pesquisa necessária à ousadia de descortiná-la. “Precisamos fazer coisas da dimensão da Amazônia; não dá para pensar pequeno, com migalhas, diante de uma coisa que talvez seja a mais importante do mundo neste momento”, afirma Spartaco Astolfi Filho, professor emérito e pesquisador da Universidade Federal do Amazonas (Ufam), em Manaus, onde há muitos anos contribui para a qualificação de capital humano nas ciências biológicas de ponta.
No advento da pandemia, equipes se mobilizaram em mutirão científico para criar um laboratório voltado ao diagnóstico da Covid-19 em tempo real, via extração de material genético do vírus, qualificando-se também para demandas de futuras doenças. Em paralelo, foi apresentado ao Instituto IPDEC, na capital amazonense, um projeto de parceria em bioinformática, que alia a biologia molecular à tecnologia da informação (TI) para análises mais rápidas, precisas e de maior escala. “É uma área fundamental ao futuro da bioeconomia”, diz Spartaco, ao advertir: “Foi preciso uma epidemia para expor a ferida da dependência de insumos básicos de saúde e a necessidade de produzi-los aqui”.
O alerta faz sentido diante da experiência vivida pelo próprio pesquisador quando trabalhava na Universidade de Brasília (UNB) e liderou, em cooperação com a empresa Biobrás, na década de 1980, o lançamento do primeiro produto de engenharia genética 100% nacional: a insulina humana produzida por bactérias transgênicas, no lugar da extraída diretamente do boi e do porco para tratamento de diabetes. A conquista gerou royalties para a universidade por alguns anos até a empresa brasileira ser comprada e engolida por uma multinacional concorrente, que interrompeu a produção nacional em favor do produto com tecnologia importada que já vendia no mercado.
O episódio atrasou o sonho brasileiro no setor, retomado mais tarde na UNB com o desenvolvimento da produção de enzima por engenharia genética – a TAQ polimerase, derivada de bactéria, com poder de amplificação de fragmentos de DNA, reduzindo custos e aumentando a rapidez do diagnóstico de doenças, entre outras aplicações. O knowhow foi levado por Spartaco junto com a bagagem para Manaus, onde chegou, em 1995, para encarar os desafios amazônicos. Na Ufam, montou o Programa Multi-Institucional de Pós-Graduação em Biotecnologia e criou o primeiro doutorado local nesta área do conhecimento, em 2012.
“A motivação estava em desenvolver novos produtos para ajudar na melhoria das condições socioeconômicas e conservação da floresta”, conta o pesquisador, também integrante do conselho científico da indústria farmacêutica brasileira Cristália, de Itapira (SP), com 113 patentes registradas e exportação para 30 países.
O risco da evasão de cérebros
Trabalhos em cooperação com a empresa ajudam na formação de pesquisadores em biologia molecular, como no caso da fabricação de hormônio de crescimento por engenharia genética, que ajudou a reduzir importações brasileiras do medicamento. Em outras frentes, biólogos usam óleo de copaíba na composição do cimento no tratamento de canal dentário, e outros controlam doenças do guaraná por meio de fungos e outros organismos que vivem dentro da própria planta.
Mas, devido à redução dos investimentos públicos em ciência, a evasão de competências formadas na Amazônia para outras regiões do País e exterior é uma realidade. “O processo deveria ser inverso”, lamenta Spartaco, ao citar exemplo da própria filha, pesquisadora que ajudou a formar e migrou para o moderníssimo mundo das startups de biotecnologia americanas.
Uma das discípulas que permanecem em Manaus é a bióloga Pamella Pimentel, doutora em biotecnologia hoje à frente startup Amazonyme junto aos sócios, também pesquisadores da Ufam, para obter enzimas de fungos da região úteis à produção de etanol de segunda geração, biocombustível extraído do bagaço da cana, farelo de milho e outras biomassas, um mercado dominado por multinacionais. “A estratégica é fornecer inovação para municiar essa disputa entre gigantes, incrementando coquetéis com o que temos de recursos genéticos na Amazônia”, explica Pimentel.
A inspiração para o negócio veio quando a pesquisadora foi finalista da Sinapse da Inovação, organizada pela Fundação Certi, em que foram apresentadas mais de 1 mil ideias inovadoras em várias áreas do conhecimento na Amazônia. O valor do prêmio foi investido no projeto, impulsionado depois pelo programa de aceleração Conecta Startups Brasil, da Softex e governo federal. Após demonstrar em pequena escala que enzimas amazônicas têm igual ou maior eficiência do que muitas existentes no mercado, o grupo começou testes com biomassa de grandes empresas de bioetanol.
“Falta ao pesquisador o ímpeto de empreender”, enfatiza a bióloga, ao lembrar que o desafio exige resiliência e que, apesar das dificuldades, a cultura acadêmica dá sinais de mudança: “Produzir algo útil de volta à sociedade ajuda a valorizar a conservação da floresta”.

Mastruz contra a Covid-19
Nos laboratórios da Ufam, patente registrada em parceria com o Instituto Nacional de Pesquisas da Amazônia (Inpa) permite o biocontrole do Aedes aegypti, mosquito transmissor da dengue e outras doenças humanas, por meio do fungo Trichoderma. Essas espécies têm sido bastante exploradas pelas habilidades na produção de enzimas de uso biotecnológico, em especial contra patógenos de plantas comerciais. Naquelas bancadas, para além do atrativo invisível de moléculas antimicrobianas, antioxidantes e anticancerígenas, a menina dos olhos é uma planta bastante popular: a velha conhecida mastruz (Dysphania ambrosioides), que ganha ares de maior importância diante da Covid-19.
No uso caseiro, a planta é normalmente batida com leite para fortalecer pulmões e tratar verminoses, entre outros males. Em laboratório, mostrou possuir um grupo de moléculas (flavonoides glicosados) que podem atingir as proteínas de replicação do novo coronavírus. Tudo começou quando os pesquisadores souberam que pessoas em Minas Gerais estavam tomando chá de mastruz e se curando da doença. “Saímos em busca de relatos etnofarmacêuticos da planta”, conta Antônia Souza, coordenadora do Laboratório de Bioensaios e Microrganismos da Amazônia. Em alguns países, como na África, por exemplo, a espécie é usada como inseticida ou no tratamento de tuberculose e doenças respiratórias, sem comprovação científica.
De posse dessas informações, os pesquisadores detectaram na planta a existência de grande quantidade de dois flavonoides: a rutina e a quercetina, já isolados de outras espécies vegetais como antioxidantes e anticoagulantes, mas não como antivirais. Eles identificaram que a forma de chá reúne maior concentração dessas moléculas, com indicação de 150 a 200 mg, três vezes ao dia. E agora aguardam o resultado de testes comprobatórios sobre a interação com o vírus da Covid-19, em cooperação com a Universidade de São Paulo. Lá, estudos científicos já identificaram drogas e um fitoterápico da farmacopeia europeia que têm rutina e quercetina e de fato conseguiram diminuir a ação do coronavírus.
“Isso comprova indiretamente o nosso trabalho: estamos avançando em três frentes, e agora, com esses resultados, é que não vamos parar”, diz Souza. Somente a mastruz tem atualmente 67 mil registros de estudos e amostras depositadas em herbários de todo o mundo, segundo o banco de dados do Global Biodiversity Information Facility (GBIF).
A importância de desenvolver e não apenas copiar
“Além da formação de recursos humanos, é necessário dar escala a soluções via interação com a indústria, e para isso as instituições da Amazônia recorrem a parcerias com centros de pesquisa de outras regiões”, aponta Souza. Ela integra a rede de pesquisas Bionorte, que ajudou a criar juntamente com o professor Spartaco, no propósito de congregar centros de ciência da região para acelerar a formação de recursos humanos.
Não faltam razões para isso. Na luta contra a resistência microbiana, a mais recente classe de antibiótico, lançada no mercado em 2015, a teixobactina, foi obtida de bactéria encontrada no solo. “Na Amazônia há várias dessas com potencial farmacêutico”, atesta a pesquisadora.
“Em vez de apenas copiar tecnologias prontas, o empresariado brasileiro precisa despertar para a biodiversidade amazônica em projetos que têm os seus riscos, mas certamente darão frutos no longo prazo”, ressalta Sérgio Duvoisin Junior, pesquisador da Universidade do Estado do Amazonas (UEA). Ele lidera um grupo de química que também rastreia enzimas de interesse industrial – da energia renovável à produção de sabão em pó e cerveja, um mercado estimado em US$ 9,9 bilhões, no ano passado, quase 40% mais que em 2018.
Cada árvore na Amazônia contém até 120 espécies de fungos, com diferentes características. Apesar do potencial, “apenas 4% deles são estudados, ou seja, a grande maioria não sabemos para que serve”, diz Duvoisin.
Em estrutura bem equipada, sua equipe iniciou neste ano um projeto pioneiro: a análise da qualidade da água da Bacia Amazônica, abrangendo 70 quesitos definidos pelas normas do Conselho Nacional de Meio Ambiente (Conama). As amostras serão obtidas por expedições a bordo de um barco-laboratório que também coletará fungos das várias regiões para estudos.
O trabalho de prospecção é chave na biotecnologia. A coleção de fungos e bactérias da Fundação Oswaldo Cruz (Fiocruz), em Manaus, guarda 2,8 mil amostras – fora o que existe em outras instituições que pesquisam a Amazônia. “Abordagem inclui não apenas doenças infecciosas, como também as degenerativas, cuja demanda se expande no mundo moderno devido ao envelhecimento da população”, revela Ormezinda Fernandes, coordenadora do Laboratório de Diversidade Microbiana da Fiocruz.
O acervo subsidia trabalhos com novos microrganismos de importância para a bioeconomia, candidatos a patentes, aproveitando a vantagem de serem facilmente extraídos da natureza e manipulados em laboratório. “Buscamos fungos capazes de produzir as mesmas substâncias achadas em plantas, de modo que essas moléculas possam ser multiplicadas”, explica Fernandes. A velocidade da engenharia genética inspira plataformas colaborativas de testagem que aproximam academia da indústria, visando ganhos de escala.
“A contar pelo mundo invisível, a Amazônia é infinitamente maior do que se imagina”, ressalta Felipe Naveca, pesquisador da Fiocruz, autor do primeiro sequenciamento do genoma completo do SARS-CoV-2 na Região Norte. Ele desenvolveu equipamento portátil de fácil manuseio para o diagnóstico molecular de doenças, com transmissão de dados por smartphone – tecnologia transferida para uma empresa de São Paulo para melhoria do protótipo inicial. Segundo o pesquisador, apesar de movimentos no sentido contrário, “a sociedade acredita na ciência e devemos difundir os resultados, até porque é ela que paga o nosso salário”.
O raio de possibilidades vai desde enzimas para alimentos nutracêuticos que fortalecem o sistema imunológico de crianças contra diarreias até pigmentos extraídos de bactérias para proteção da pele contra raios UV em cosméticos. Em 2019, pesquisadores do Inpa publicaram a descoberta de 17 novos cogumelos amazônicos com potencial na indústria alimentícia ou farmacêutica. Um deles, da espécie Përɨsɨ (Marasmius yanomami), tem estrutura fibrosa e é usado por indígenas Yanomami, no Amazonas, para confeccionar cestarias.
Patentes relevam o atraso
A “mineração gênica”, com a síntese de moléculas capazes de concentrar e reproduzir efeitos desejados, seja para curar doenças, melhorar a produção agrícola ou combater a poluição, é a bola da vez no mundo da biotecnologia. “O nosso potencial como país megadiverso não está sendo explorado à altura”, conclui Irene von der Weid, pesquisadora do Instituto Nacional de Propriedade Industrial (INPI).
Levantamento sobre patentes depositadas no Brasil entre 2010 e 2016, envolvendo 12 setores da biotecnologia, mostrou que a maioria se concentrou nas áreas de saúde, agronomia e meio ambiente, e partiu principalmente de universidades. Dos 1.583 registros analisados, a Região Norte ficou em último lugar, com apenas 30 no período.
Os números retratam a desigualdade regional e o desconhecimento sobre a biodiversidade oculta da Amazônia, apesar de instituições do Sul ou Sudeste também patentearem produtos de fungos e bactérias da região. “Enquanto na maioria dos países a biotecnologia representa em média 6% a 7% das patentes, no Brasil o índice é de 3,5% a 4%”, revela Weid, para quem há uma outra questão preocupante: a inexistência de um banco brasileiro para o depósito obrigatório do material biológico relativo a esses registros, conforme o Tratado de Budapeste. O destino principal é Estados Unidos e Alemanha, segundo o estudo.
Pesquisadores reclamam da demora de oito a 10 anos para conclusão de um processo de patente no Brasil, além dos custos. Outro entrave à bioeconomia é a dificuldade da licença para acesso a recursos genéticos: “A saída tem sido trabalhar em grandes redes de pesquisa para compartilhamento de licenças necessárias a publicações científicas”, afirma Neliton Marques, coordenador do Programa de Pós-Graduação em Ciências do Ambiente e Sustentabilidade na Amazônia, na Ufam.
A equipe do pesquisador trabalha com extratos botânicos capazes de matar ou repelir pragas associadas a plantas cultivadas comercialmente, suprindo a demanda da produção orgânica. Constatou-se, por exemplo, que o timbó –o mesmo usado tradicionalmente por indígenas para capturar peixes devido à seiva tóxica – é bastante eficaz contra a mosca-branca, prejudicial ao milho, feijão e outras culturas agrícolas.
Em outras linhas de trabalho, o inseto é bem-vindo, como no caso das larvas da mosca soldado-negra, reproduzidas pela startup Sustente, de Manaus, com o objetivo de tratar resíduos orgânicos de restaurantes, feiras e supermercados e, com isso, transformar a solução em negócio. Hoje as empresas gastam R$ 290 por tonelada para destinar esse lixo aos aterros, com poluição do solo e liberação de metano – potente gás associado à mudança climática. “Nosso foco atual é o tratamento biológico de resíduos, mas podemos também gerar ração animal e biofertilizante como subprodutos”, diz pesquisador Nelson Poli.
O empreendedor iniciou o projeto na universidade e agora aguarda a retomada pós-pandemia para se estabelecer e avançar neste mercado, que ainda engatinha no País. Após a licença ambiental, obtida em 2019, o plano é processar 5 toneladas por dia de resíduos orgânicos, em especial das empresas do Polo Industrial de Manaus. “A produção local de ração, sobretudo à piscicultura, é estratégica diante das dificuldades logísticas da região”, justifica Poli, lembrando que a solução baseada em inseto tem a vantagem adicional de substituir o farelo de soja, obtido por monoculturas de impacto ambiental.
A referência do açaí
No caso de outra startup de Manaus, a Biozer da Amazônia, os olhares estão no “ouro roxo” – o açaí, usado na composição de um gel de limpeza facial, entre outros produtos naturais do portfólio. Com certificação árabe Halal, a novidade será lançada no mercado em setembro, na concorrida feira Beautyworld Middle East, em Dubai. “A sustentabilidade, com a conservação da floresta, é um precioso atributo de venda”, aponta o CEO da empresa, Carlos Danniel.
O novo cosmético, recém-desenvolvido via PPBio, com investimento de empresas beneficiadas pela isenção fiscal da Zona Franca de Manaus, é um exemplo prático do modelo de fomento também aberto a tecnologias de enfrentamento à Covid-19. A trajetória do açaí com suas propriedades nutricionais e antioxidantes, e valor de mercado que já supera entre seis a oito vezes o da soja, por hectare, mostra o que pode se repetir com novas soluções amazônicas à saúde. O fruto já movimenta uma cadeia econômica de R$ 1,2 bilhão ao ano, com exportação para se transformar lá fora em subprodutos mais refinados e valiosos.
O sucesso ilustra bem o potencial escondido na floresta, porém expõe os desafios a superar quanto ao aspecto ambiental e condições de vida e trabalho na ponta inicial da extração do produto – e nisso uma bioeconomia de vanguarda, pautada por princípios de sustentabilidade e de comércio justo, tem a contribuir.
Pará aposta no bioplástico do cacau
Na vitrine principal como hit da onda fitness, o açaí atrai atenção de diferentes esforços de pesquisa – da biossegurança no processamento como alimento à durabilidade na prateleira. “Precisamos de investimento pesado para recuperar o atraso de pelo menos 15 anos em relação aos países mais avançados”, observa Hervé Rogez, coordenador da rede Bionoma, criada em 2016 para unir pesquisadores de bioprocessos em diferentes áreas e fazer a ponte com o setor privado, no Pará. O caroço do açaí, por exemplo, é trabalhado como biomassa para gerar energia.
O Parque de Ciência e Tecnologia Guamá, em Belém, primeiro do gênero a entrar em operação na Amazônia, mantido pelo governo estadual, é base para a oferta de soluções. No campo de novos materiais, a startup Biomimética, composta por alunos da Universidade Federal do Pará, desenvolveu bioplástico comestível a partir da casca de cacau, na forma de microfilme para conservação de alimentos nos pontos de venda. A inovação paraense foi campeã da HackBrazil 2020, após mentoria da Universidade de Harvard e Instituto de Tecnologia de Massachusetts, nos Estados Unidos.
“É preciso mudar a antiga lógica das drogas do sertão, baseada no extrativismo que deixa pouco desenvolvimento”, pondera Amarílis Aragão, assessora técnico-científica da Biotec-Amazônia, em Belém, organização criada para mapear competências, atrair investimentos e executar o programa estadual de bioeconomia. “É incoerente ter a maior diversidade do mundo e o pior Índice de Desenvolvimento Humano (IDH) do País, registrado em Melgaço, município da Ilha do Marajó”, completa Aragão.
A instituição coordena o Centro de Desenvolvimento Regional (CDR) instituído neste ano, na Amazônia, pelo Ministério da Educação. O objetivo é identificar e apoiar projetos de interesse do território, com prioridade em bioprodutos, energia renovável e valorização de serviços ambientais. Para Aragão, o modelo ideal vai na contramão de experiências como a da pilocarpina, “valioso ativo farmacêutico extraído do jaborandi na floresta em Carajás (PA), beneficiado no Piauí e exportado para a produção colírio na Alemanha, que o vende de volta a preço de ouro no Brasil, com poucos benefícios aos extrativistas”.
Ratificado neste ano pelo Congresso Nacional após uma década, o Protocolo de Nagoya – acordo internacional que versa sobre o acesso a recursos genéticos e a repartição justa e equitativa dos benefícios advindos de sua utilização – pode induzir novos caminhos. É a base de sustentação para pesquisas de novos processos e produtos de amplo consumo: xampus, remédios, combustíveis e até itens dos cardápios de chefs de cozinha. Movimentos em busca de bem-estar e vida saudável abrem perspectivas e novidades têm chegado ao mercado, mas não em ritmo aquém do potencial brasileiro.
Protocolo de Nagoya traz mais segurança
Na análise de Bráulio Dias, professor do Departamento de Ecologia da Universidade de Brasília e ex-diretor geral da Convenção sobre Diversidade Biológica (CDB), da qual se originou o Protocolo, a primeira geração de leis nacionais sobre o tema teve foco restritivo, baseado no combate à biopirataria. “No entanto, não haverá repartição de benefícios se países detentores da biodiversidade não facilitarem o acesso a seus recursos genéticos com estímulo à P&D e se as empresas não tiverem segurança jurídica para trazer os investimentos necessários a transformar isso em riqueza econômica”.
A estratégia de avançar na bioeconomia requer investimentos de risco e, para isso, é essencial clareza nas regras. Segundo Dias, apesar de representar apenas 2% da ciência mundial, no campo específico da biodiversidade o Brasil detém 10% das pesquisas, muitas interligadas com laboratórios de ponta em outros países. A Amazônia, porém, está atrás da fila com minguados 5% dos investimentos brasileiros em ciência e tecnologia.
Estão em jogo, “avanços na química, genômica e computação que permitem brincar com moléculas encontradas na natureza para realçar princípios ativos desejados para diversas aplicações”. Sem isso, diz o professor, “o País continuará visto como grande fornecedor commodities primárias, entre elas a madeira ilegal”. Mesmo assim, até esse padrão exportador de grãos, carne e minérios está sob risco em função da pressão internacional de investidores e consumidores contrários à destruição da Amazônia.
Cerca de 47% da região é legalmente protegida como reservas ambientais e terras indígenas. “Isso deve ser um entrave ao desenvolvimento econômico?”, pergunta o pesquisador do Inpa Adalberto Val, em seminário virtual da Academia Brasileira de Ciência sobre o tema, que envolve o debate sobre mudanças de paradigma. Ele relembra as reflexões da geógrafa Berta Becker (1930-2013), para quem, a respeito do que fazer na Amazônia, não existe um modelo a ser copiado simplesmente porque não há qualquer país tropical desenvolvido com a economia baseada em recursos sofisticados da floresta.
Pioneira no pensamento sobre a bioeconomia amazônica, Becker dizia: assim como o Cerrado se tornou grande produtor mundial de alimentos como resultado das pesquisas da Embrapa, o Vale do Paraíba se destacou como referência na indústria aeronáutica em função da Embraer, e polos do interior de São Paulo prosperaram no campo dos biocombustíveis com a revolução do Proálcool, igual vigor deveria ser empreendido para a transformação da Amazônia em meca da bioeconomia com base na floresta.
“Sem ciência e sem conhecimento tradicional não há bioeconomia, e não podemos simplesmente transportar para a floresta o atual modelo de desenvolvimento de retorno rápido, vigente na economia convencional”, completa Carlos Alfredo Joly, coordenador do programa Biota-Fapesp. Ele reforça que a química moderna “pode quase tudo”, mas que “conseguiremos avançar mais rápido a partir de moléculas selecionadas pela natureza ao longo de milhões de anos de evolução”.
Nos Estados Unidos, produtos agrícolas baseados em microbioma (conjunto de microrganismos e seus genes) deverão movimentar um mercado de mais de US$ 10 bilhões até 2025. Na área médica americana, os investimentos neste campo chegaram a US$ 1,7 bilhão na última década, refletindo uma tendência global.
Mais de um quinto dos novos medicamentos lançados no mercado mundial a cada ano são derivados da biotecnologia, segundo o Instituto de Ciência e Pós-Graduação para o Mercado Farmacêutico. O cenário se apresenta desafiador à competitividade do setor no Brasil, que cresceu, nas últimas duas décadas, por meio da cópia de produtos sintéticos que perderam a patente.
Desta forma, a realidade nacional está longe de inovações como terapias gênicas, biossensores que detectam doenças, bioimpressão de órgãos humanos para transplante e substituição de animais em testes de medicamentos por meio de biochip (órgãos-em-chip).
Expedição nos rios amazônicos e o paradoxo do desmatamento

Parte desse arsenal pode se valer de insumos da floresta, encontrados em sedimentos da Bacia Amazônica, objeto de investigação do pesquisador Gilvan Ferreira da Silva, da Embrapa Amazônia Ocidental, em Manaus. Após expedições inéditas de coleta em 6 mil km de rios, mais de 1 mil microrganismos foram isolados – tanto os cultiváveis em laboratório (5%) como os que apresentam moléculas de interesse e só podem ser multiplicados pelo acesso ao código genético (95%), visando a transformação em produtos. A meta para este ano é obter o genoma completo de mais de 60 bactérias já selecionadas.
O alvo estava em fungos e bactérias de interesse agrícola capazes de combater fitopatógenos e disponibilizar nutrientes às plantas. Mas também foram encontradas moléculas com ação antiparasitária e anticancerígena, além das que agem na produção de enzimas para atividades industriais, como amaciamento de fibras de jeans na indústria têxtil e produção de detergentes e biodiesel. “Queremos mostrar à população que o meio ambiente vale muito mais quando conservado, para que assim possamos explorar esse material”, afirma Silva.
A preocupação faz sentido, porque as queimadas e o desmatamento, que bateu recorde em 2020, colocam esse patrimônio em risco. Embora pareça um inexplicável paradoxo, neste momento também a derrubada de árvores está no rol de superlativos tão característicos da Amazônia, responsável por 42% dos gases de efeito estufa emitidos no Brasil.
A bioeconomia, que depende da floresta bem conservada para existir, pode ser um escudo contra a devastação. Em paralelo, as lições da Covid-19 e a corrida mundial para se chegar a uma vacina ajudam a valorizar a ciência e tecnologia como solução. Da fauna e flora têm saído dois novos vírus por ano com poder de nos atingir. E a prevenção, segundo pesquisadores, custa somente 2% do prejuízo econômico causado pela atual pandemia ao planeta, ao menos US$ 5 trilhões em 2020. Quando o mundo e o Brasil acordarem do pesadelo poderão, enfim, abrir os olhos e ver que muitas dessas respostas podem estar na Amazônia.
![]() |
Republicado da Página 22 através de parceria de conteúdo. |
Leia Também
Ibama gastou só 20% do orçamento para fiscalização até julho
Plantas da Mata Atlântica têm propriedades medicinais de potencial ainda desconhecido
Se o que você acabou de ler foi útil para você, considere apoiar
Produzir jornalismo independente exige tempo, investigação e dedicação — e queremos que esse trabalho continue aberto e acessível para todo mundo.
Por isso criamos a Campanha de Membros: uma forma de leitores que acreditam no nosso trabalho ajudarem a sustentá-lo.
Seu apoio financia novas reportagens, fortalece nossa independência e permite que continuemos publicando informação de interesse público.
Escolha abaixo o valor do seu apoio e faça parte dessa iniciativa.
Leia também
Sobre Hitchcock, desmatamento e o pesadelo ambiental
Parece que o trio Bolsonaro-Mourão-Salles (BMS) andou sonhando com a política ambiental brasileira. O resultado do sonho? Um tal de Conselho da Amazônia →
Plantas da Mata Atlântica têm propriedades medicinais de potencial ainda desconhecido
Segundo a Organização Mundial de Saúde, 80% da população dos países em desenvolvimento utilizam práticas tradicionais em seus cuidados básicos de saúde e 85% usam plantas medicinais →
Ibama gastou só 20% do orçamento para fiscalização até julho
Multas caíram pela metade no mesmo período; dados do governo apontam corte de 16,7% no orçamento para 2021 →


